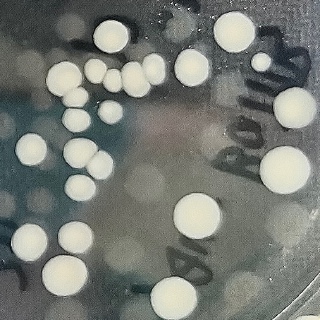

想问问怎么用matlab来实现这张图的菌落计数

你好,我是有问必答小助手,非常抱歉,本次您提出的有问必答问题,目前超出我们的服务范围,暂时无法为您解答。
首次提问人员可免费体验一次有问必答服务。目前首次提问的问题服务范围为:编程语言、Java开发、python、数据库、前端开发 领域专业技术问题,为您提供问题的解决思路和指导。不提供源码代写、项目文档代写、论文代写、作业代写、安装包资源发送或安装、软件使用指导等服务。
我们后续会持续优化,扩大我们的服务范围,为您带来更好地服务。
你好,我是有问必答小助手,非常抱歉,本次您提出的有问必答问题,目前超出我们的服务范围,暂时无法为您解答。
首次提问人员可免费体验一次有问必答服务。目前首次提问的问题服务范围为:编程语言、Java开发、python、数据库、前端开发 领域专业技术问题,为您提供问题的解决思路和指导。不提供源码代写、项目文档代写、论文代写、作业代写、安装包资源发送或安装、软件使用指导等服务。
我们后续会持续优化,扩大我们的服务范围,为您带来更好地服务。